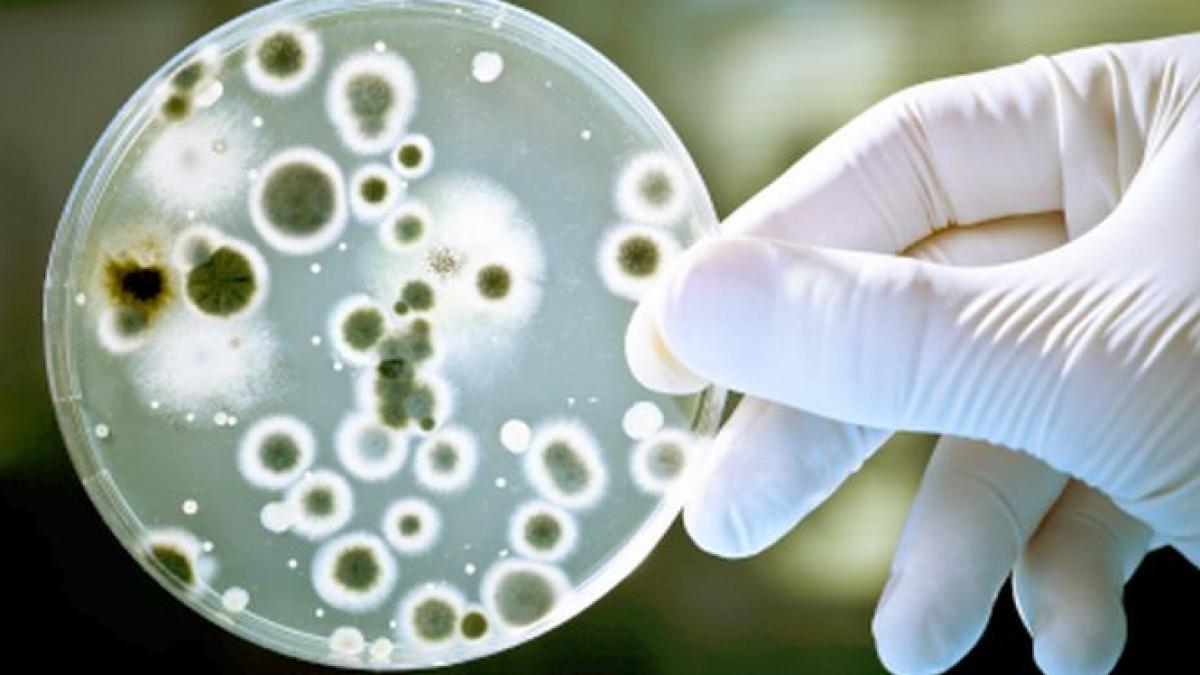
apa infestata cu bacterii periculoase la robinetele romanilor

Antena 3 CNN
›
Bistriţa
Bistriţa | Pagina 6

Bistriţa este municipiul de reședință al județului Bistrița-Năsăud, Transilvania, România, format din localitățile componente Bistrița (reședința), Ghinda, Sărata, Sigmir, Slătinița, Unirea și Viișoara.
Bistriţa este și cel mai mare oraș din acest județ, cu o populație de 75.076 locuitori (potrivit recensământului din anul 2011). Ocupă o suprafață de 14.547 hectare.
Bistriţa este și cel mai mare oraș din acest județ, cu o populație de 75.076 locuitori (potrivit recensământului din anul 2011). Ocupă o suprafață de 14.547 hectare.
Eşti pe pagina 6 din 8 a ultimelor ştiri despre Bistriţa publicate pe Antena 3.